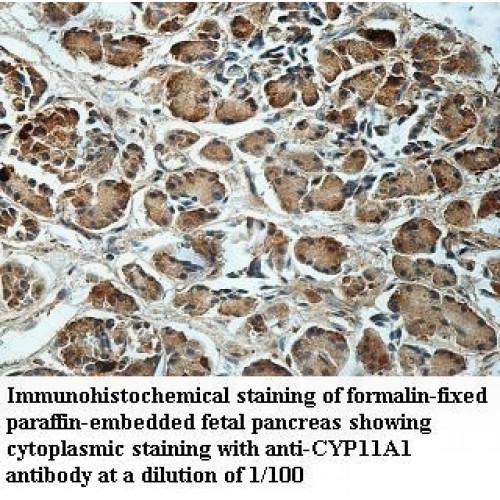
CYP11A1 Antibody

Cart 0 Product Products (empty)
No products
Free shipping! Shipping
$0.00 Total
Product successfully added to your shopping cart
Quantity
Unit
Total
There are 0 items in your cart. There is 1 item in your cart.
Total products (tax excl.)
Total shipping (tax excl.) Free shipping!
Total (tax excl.)
Antibodies and Kits
- Protein Control Ligand
- Pathway Inhibitors
- Enzyme Inhibitors
- Kinase Inhibitors
- Protease
- Synthase
- p18
- p38
- p53
- p70
- p90
- Peptidase
- Carboxyl and Decarboxylases
- Ceramide Turnover Enzymes
- Chromatin Modifying Enzymes
- Cyclic Nucleotide Turnover Enzymes
- Glycerophospholipid Turnover Enzymes
- Hydroxylases
- Ubiquitin-Activating Enzyme
- Adenosine Deaminase
- Clathrin
- Nuclease
- p68
- ACE
- COX
- DHFR
- Neprilysin
- NF-κB
- RAF
- RAS
- Reductase
- ROR
- Topoisomerase
- Transferase
- Protein Inhibitors
- Transporter Inhibitors
- Cell Inhibition
- Synthase
- Receptor Tyrosine Phosphatases (RTP)
- AChE
- Peptidase
- Autophagy
- Toll-Like Receptor (TLR)
- Enzyme Inhibitors
- Function Modulators
- Activators
- G Protein-Coupled Receptor Ligands
- 5HT Receptors
- Adrenoceptor
- Angiotensin Receptor
- Cannabinoid Receptors
- CCK Receptors
- DA Receptors
- EAA Receptors
- Ghrelin Receptors
- GABA Receptors
- Histamine Receptors
- Leukotriene Receptors
- Metabotropic Glutamate Receptors
- Motilin Receptors
- Muscarinic Receptor
- Neuropeptide Receptors
- Opioid Receptors
- Orexin Receptors
- Orphan Receptors
- Prostanoid Receptors
- Proteinase-Activated Receptors
- Purinergic Receptors
- Ryanodine receptor
- Sigma Receptors
- Thrombin Receptor
- Vaniloid Receptor
- VIP and PACAP Receptors
- Neurotensin Receptors
- Urotensin Receptor
- Imidazoline receptor
- SMO Receptors
- Apelin Receptor
- β-arrestin/β2-adaptin
- KDM4
- Glucocorticoid Receptor
- Laminin Receptor
- AHR
- Amylin Receptor
- Bombesin Receptor
- Bradykinin Receptor
- CFTR
- CGRP Receptor
- CRFR
- Endothelin Receptor
- Ephrin Receptor
- Farnesoid X receptor (FXR)
- Glucagon Receptor
- Nuclear Receptor Ligands
- GDNF Receptors
- TNF Receptors
- Transcription Factors
- Chemokines
- Cytokine Receptors
- Biomarkers and Buffer Solutions
- Molecular Probes
- Stem Cell Research
- Alzheimer's Disease
- Apoptosis
- Cancer Research
- Epigenetics
- Metabolites
- PET/SPECT Imaging Precursors
- Customized Screening Library
- Ultra Pure Pharmacological Standard
- Tissue Microarray (TMA)
- Proteins and Antibodies
- Primary Cells
- ELISA KIT
- Natural Products
- Lab Equipments
- Humanized Mice for PDX Platform
- Rare Chemicals
- Custom Synthesis
- Antibacterial
- Antifungal
- Antioxidant
- Antiviral
- Molecular Glues
- PROTAC Linker
- SARS-CoV
CYP11A1 Antibody
NCTP08366
Description: Rabbit polyclonal to human CYP11A1
Application: ELISA, IHC
Reactivity: Human
Catalog #: NCTP08366
$360.00
1000 Items
Molarity Calculation Cart®
HOW TO ORDER
More info
| DESCRIPTION | |
| Species Reactivity | Human. Predicted: rat and mouse. Other species not tested. |
| Isotype | IgG |
| Immunogen | Recombinant human CYP11A1 protein 56-297aa. |
| Accession # | P05108 |
| Alternative Names | Cholesterol side-chain cleavage enzyme, mitochondrial, CYPXIA1, Cholesterol desmolase, Cytochrome P450 11A1, Cytochrome P450(scc), CYP11A |
| Purification | Purified by protein affinity column. |
| Formulation | Lyophilized with 1% BSA and 0.02% NaN3. |
| Size | 100µg/200µl |
| APPLICATION | |
| ELISA | 1:20,000 – 1: 80,000 |
| Immunohistochemistry | 1:100-1:500 |
| - | For research use only. Optimal dilutions/concentrations should be determined by each laboratory for each application. |
| PREPARATION AND STORAGE | |
| Reconstitution | Reconstitute in 200µl of sterile H2O. |
| Storage | Shipped at ambient temperature. Store immediately at -20°C upon receipt. Avoid repeated freeze-thaw cycles. |
| REFERENCES | |
| - | Lee M, Marinoni I, Irmler M et al. Transcriptome analysis of MENX-associated rat pituitary adenomas identifies novel molecular mechanisms involved in the pathogenesis of human pituitary gonadotroph adenomas. Acta Neuropathol. 126 (1), 137-150 (2013). |